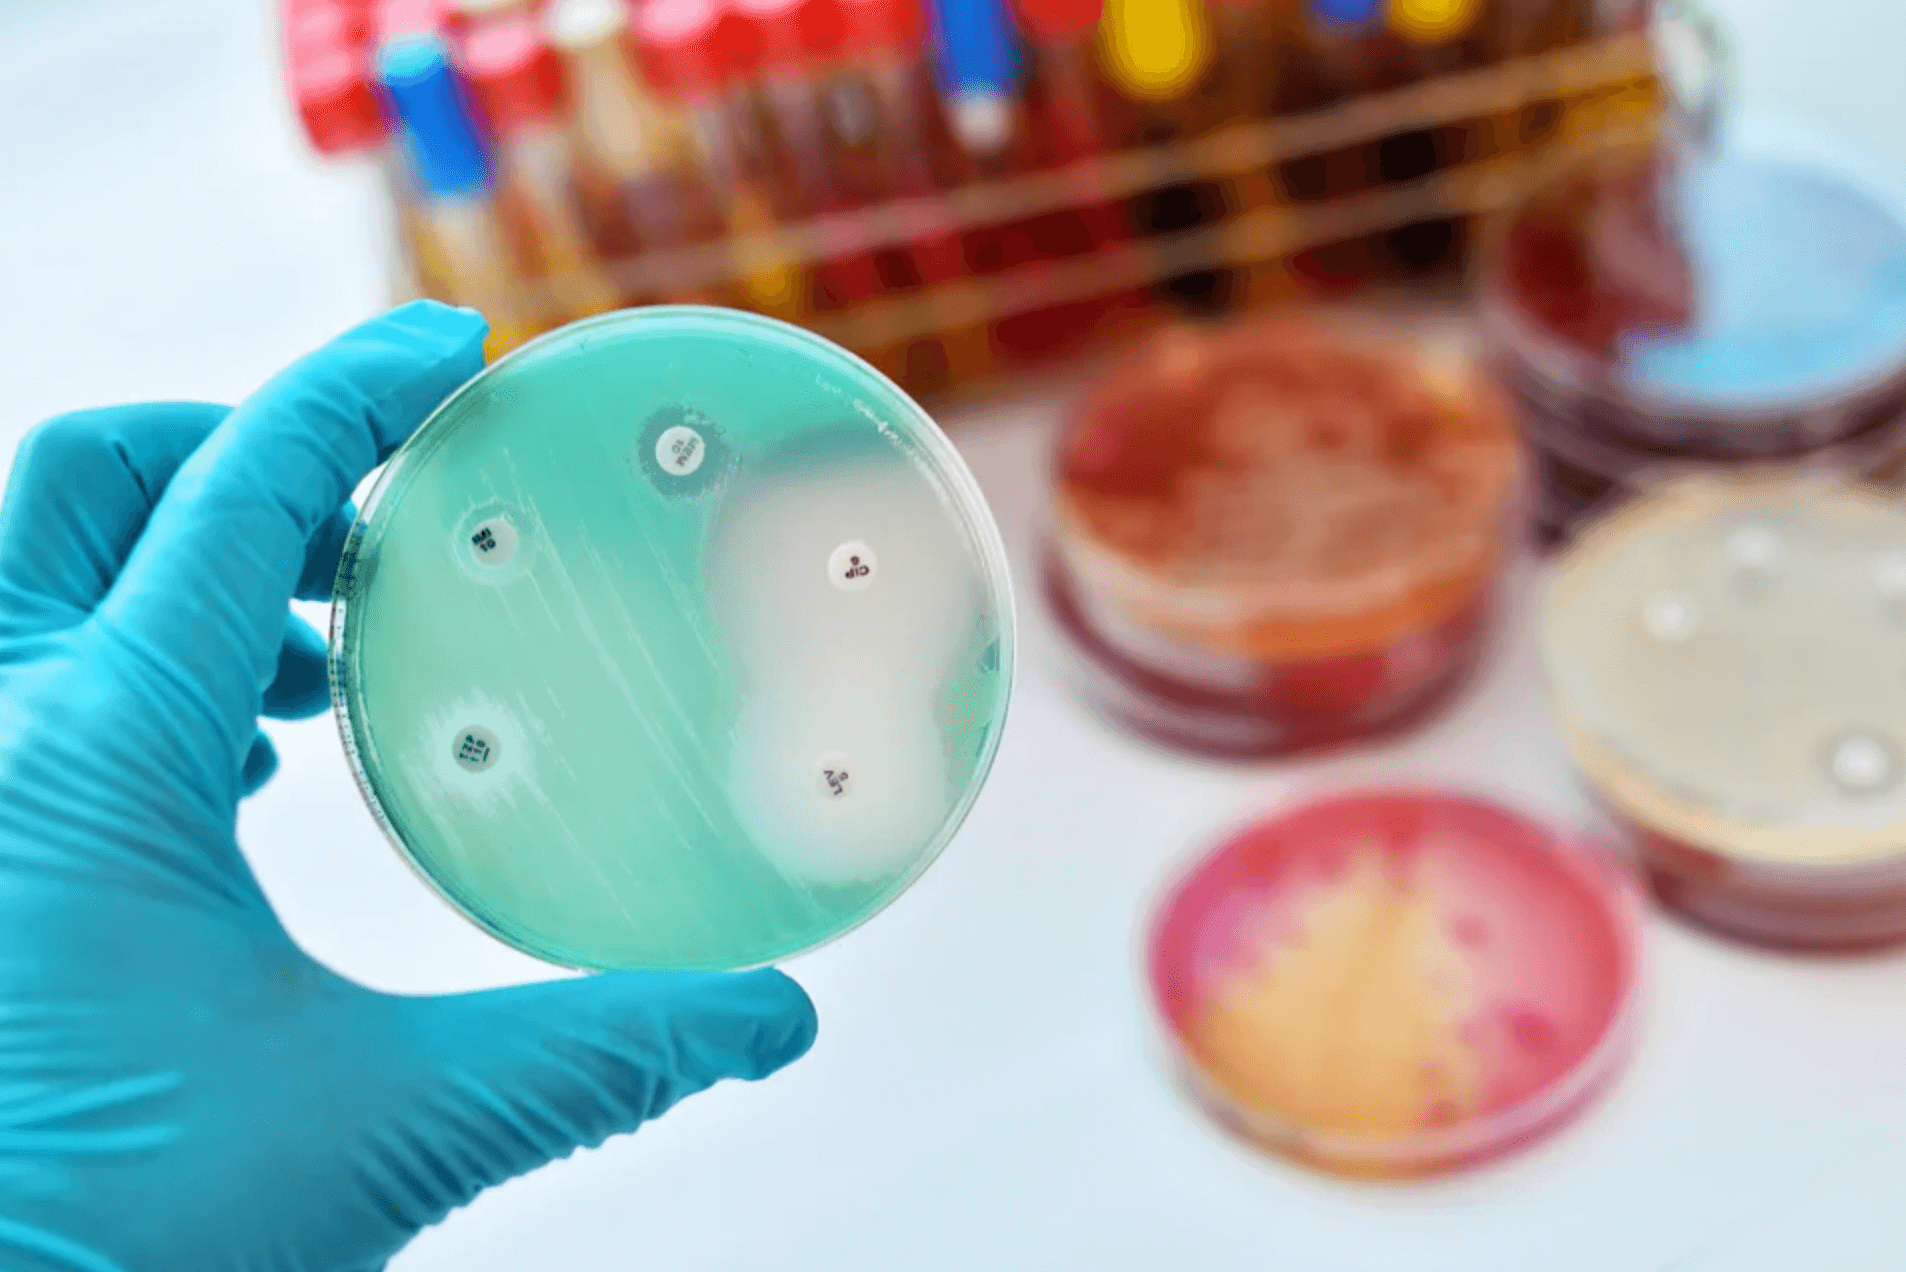
항생제

항생제 부작용 내성 원인
- 암 건강
- 2022. 9. 2. 20:32
항생제는 박테리아를 없애거나 성장을 늦추는데 사용하는 약물입니다. 여기에는 다양한 약물이 포함되며 박테리아로 인한 질병을 치료하는데 주로 사용이 됩니다. 그러나 이러한 항생제를 함부로 남용힌디먄 부작용 및 내성의 원인이 되기에 기본적인 정보가 필요합니다. 아래 항생제 부작용 및 내성에 대한 원인의 정보를 공유하도록 하겠습니다.

항생제 내성 원인
항생제 내성은 박테리아에서 자연적으로 발생할수 있으며, 우리의 행동은 저항의 발달과 확산을 증가 시킬수 있습니다. 항생제의 내성의 주요 원인은 항생제 사용입니다. 항생제를 사용하면 일부 박테리아는 죽지만 내성 박테리아는 생존하고 증식할수 있습니다.
항생제를 더 많이 사용할수록 박테리아가 항생제에 내성을 가지게될 가능성이 높아지고, 항생제가 미래에 필요할때 제대로 작동하지 않을수 있습니다. 항생제 사용을 줄이면 항생제가 박테리아를 죽이는데 다시 효과적일수 있습니다.
우리나라는 특히 어린아이부터 항생제를 너무 무분별하게 사용하는 경향이 있습니다. 최대한 불필요한 항생제는 사용하지 않는게 좋으며 박테리아는 아래와 같은 경우 항생제 내성을 가질수 있습니다.
- 다른 박테리아로부터 내성 유전자를 받을경우
- 과도한 항생제를 사용할 경우
- 항생제로 부터 박테리아 스스로 보호하기 위해 변경하는 경우
▣ 항생제가 효과 없는경우
항생제는 박테리아에 의한 감염에만 효과가 있으며, 감기나 독감과 같은 바이러스성 감염에는 효과가 없으므로 바이러스 감염의 경우 항생제를 절대 사용하지 않아야 합니다.
▣ 항생제 빠른 정보
- Alexander Fleming은 1928년 최초의 천연 항생제인 페니실린을 발견
- 항생제는 바이러스 감염과 싸울수 없음
- Fleming은 항생제 내성의 증가를 예측
- 항생제는 박테리아를 죽이거나 성장을 느리게 함
- 부작용으로는 설사, 배탈, 메스꺼움등이 발생할수 있음
유레아플라즈마 유레아리티쿰 증상 원인
유레아플라즈마 유레아리티쿰(ureaplasmaurealyticum) 들어보셨나요. 유레아플라즈마는 사람들의 요로 또는 생식 관에서 흔히 발견되는 박테리아입니다. 신체의 박테리아 개체군의 일부이며, 대부분
bluelsm.com
▣ 박테리아가 퍼지는 방법
- 직접 접촉하거나 만지는경우
- 기침과 재채기
- 체액에 대한 노출 밀접한 개인접촉등
이밖에 박테리아는 오랜기간 동안 표면에서 살수 있으므로 일상적인 물건을 만지면 박테리아에 걸릴수 있습니다. 그래서 병원에 다녀온 경우 꼭 손을 깨끗이 씻는게 좋습니다.
또한 해로운 박테리아에 오염된 음식물이나 섭취할때 박테리아에 노출될수 있으며, 박테리아는 직접적인 접촉을 통해 동물과 사람 사이를 이동할수 있습니다.

항생제 부작용
항생제는 페니실린과 같은 살균 항생제는 박테리아를 죽일수 있습니다. 이러한 약물은 일반적으로 박테리아 세포벽의 형성 또는 세포 내용을 방해하며 정균제는 박테리아가 증식하는것을 막을수 있습니다. 그러나 이러한 항생제 또한 상당한 부작용이 있습니다.
항생제를 남용하거나 잘못사용하면 박테리아가 내성을 가지게 되는 부작용을 일으킬수 있으며, 특정 항생제를 장기간 사용할경우 소화기관 및 질의 곰팡이 감염이 생길수 있습니다. 아래 항생제 부작용에 대한 정보를 공유합니다.
▣ 항생제 가장 흔한 부작용
항생제의 가장 흔한 부장용으로는 소화기 계통에 문제가 발생하는것이며, 이는 10명중 1명꼴로 흔하게 발생합니다. 증상으로는 아래를 참고하세요.
- 메스꺼움
- 구토 토할것 같음
- 설사, 복통
- 팽만감과 소화불량
- 식욕 없음
▣ 항생제 알레르기 반응
외국 자료를 보면 15명중 1명이 항생제 특히 페니실린과 세팔로스포린에 알레르기 반응을 보입니다. 대부분의 경우 알레르기 반응은 경증에서 중등도이며, 아래와 같은 증상이 나타날수 있습니다.
- 기침
- 천명
- 호흡곤란을 유발할수있는 인후의조임
- 피부발진 두드러기
이러한 경증에서 중등도의 알레르기 반응은 항히스타민제를 복용하여 치료할수 있지만, 조금더 심각하거나 걱정이 될때는 가까운 병원을 방문하거나 전문가의 조언을 구하면 좋습니다.
다만 드물게 나타날수 있는 항생제 아나필락시스는 생명을 위협할수 있는 알레르기 반응이기 때문에 바로 119와 같은곳에 연락을 하여 응급조치를 받으셔야 합니다. 증상은 아래와 같습니다.
- 호흡곤란 점점빨라지고 얕은 호흡
- 어지러움 및 실신
- 천명
- 빠른 심장박동
- 혼란과 불안
- 온몸에 땀이 흐름
▣ 심장 질환
플루오로퀴놀론 항생제는 심장 팍막 문제의 위험이 있는 사람들에게 심각한 부작용을 일으킬수 있으며 아래와 같은 심각한 부작용이 나타나면 플루오로퀴놀론 항생제를 즉시 중단하고 병원에 가야합니다.
- 발목이 붓거나, 발 및 다리에 부종
- 심장 두근거림
- 갑작스러운 호흡곤란
처방전 항생제 부작용 줄이는방법
항생제의 과다 사용은 박테리아로 부터 항생제 내성을 만들수 있습니다. 그렇다고 의사가 처방해주는 항생제를 몸이 조금 나아졌다고 먹다가 그만 먹으면 절대 안됩니다. 한번에 확실하게 박테리아를 처리하기위해 의사가 처방한 항생제는 의사의 지시대로 끝까지 다 섭취하여야 합니다.
- 괘찮아 졌다고 바로 항생제 투여를 중단하지 않는다
- 바이러스 감염에는 복용하지 않는다
- 의사가 처방한 약을 복용함
- 복용하는 약을 건너 뛰지 않는다
- 의사가 처방한 기간동안 복용한다
내성이 생기지 않게 하기위해 의사가 처방한 기간까지 항생제를 복용하고 복용하는 동안 약을 건너 뛰지 않고 그때 그때 잘 복용할수 있도록 하는것이 중요합니다. 그리고 임의대로 예전에 지어놓은 항생제를 스스로 판단하여 절대 복용하지 마세요.
이상으로 항생제 부작용 내성 원인 포스팅을 줄입니다.
CRE균 증상 감염 경로 원인
얼마전 VRE균에 대해 알아봤는데요, 오늘은 CRE균 증상 및 감염 경로에 대해서 알아볼가 합니다. 무분별한 항생제의 남용으로 인하여, 초강력 항생제 마저 내성이 생기게 되었습니다. 이는 면역성
bluelsm.com
VRE균 증상 전염경로 감염
슈퍼박테리아 이런이야기를 들어봤을겁니다 VRE균, CRE균등이 있는데요 오늘은 VRE균에 대해서 그 증상과 어떤 경로로 전염이 이루어지는지 그에 대하여 이야기를 진행할가 합니다. VRE환자는 갈
bluelsm.com
'암 건강' 카테고리의 다른 글
| 갑상선 초음파 두경부 침샘 초음파 비용 (0) | 2022.10.08 |
|---|---|
| 대웅제약 에너씨슬 콜레다운 효능 (0) | 2022.09.23 |
| 프롤로주사 부작용 효능 통증 후기 (0) | 2022.09.08 |
| 삭센다 부작용 효과 총정리 (2) | 2022.09.05 |
| 초임계 알티지 오메가3 추천 효능 (1) | 2022.08.30 |
| 어금니 금니 가격 요즘 얼마 (0) | 2022.08.19 |
| 어금니 임플란트 가격 뼈이식 비용 (0) | 2022.08.16 |
| 3일 디톡스 다이어트 효과 부작용 (2) | 2022.08.10 |
이 글을 공유하기






